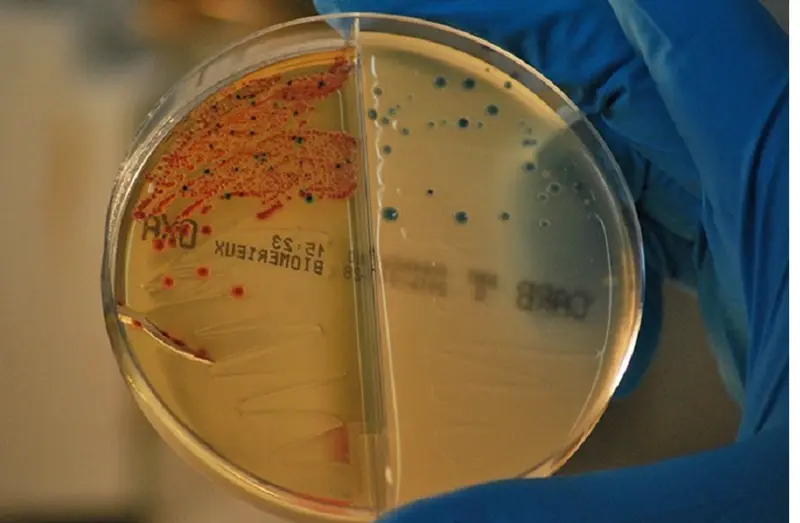
<p> Archivo - Bacterias resistentes a los antibi&oacute;ticos aisladas en el IRYCIS. / - JER&Oacute;NIMO RODR&Iacute;GUEZ BELTR&Aacute;N - Archivo </p>

Un nuevo antibiótico puede combatir bacterias que no responden a otros tratamientos
Un grupo de científicos de la Universidad Rockefeller (Estados Unidos) han experimentado en animales un antibiótico potente contra las bacterias que no responden a otros tratamientos, como pueden ser patógenos como Acinetobacter baumannii.
El estudio que se ha publicado en la revista 'Nature' recoge la preocupación que padecían los investigadores por un amplio grupo de bacterias que circulan en los hospitales y pueden esquivar no solo medicamentos de gran éxito como la penicilina y la tetraciclina, sino incluso la colistina, un antibiótico utilizado durante mucho tiempo como última opción crucial.
Al respecto de este fármaco, los investigadores creen que la colistina se ha utilizado abundantemente durante mucho tiempo en la industria ganadera y, más recientemente, en la clínica. Se cree que el uso excesivo ejerció una fuerte presión evolutiva sobre las bacterias, obligándolas a desarrollar nuevos rasgos para sobrevivir. Como resultado, algunas especies han adquirido un nuevo gen llamado* mcr-1, que evade la toxicidad de la colistina, lo que hace que estas bacterias sean resistentes al fármaco.
El investigador principal del estudio, Zongqiang Wang, y su grupo de trabajo han realizado esta investigación a raíz de cuestionarse si existen compuestos naturales que puedan usarse para combatir las bacterias resistentes a la colistina. Así, añade Wang, en la naturaleza, las bacterias compiten constantemente por los recursos, desarrollando nuevas estrategias para frustrar las cepas vecinas.
De hecho, la colistina en sí es producida por una bacteria del suelo para eliminar a los competidores. Si un rival se resiste al ataque recogiendo mcr-1, el primer microbio podría adquirir posteriormente una nueva mutación, lanzando una nueva versión de colistina capaz de matar la bacteria mcr-1.
Seguidamente, examinaron más de 10,000 genomas bacterianos, encontraron 35 grupos de genes que predijeron que producirían estructuras similares a la colistina. Un grupo parecía particularmente interesante ya que incluía genes que eran lo suficientemente diferentes de los que producen colistina como para sugerir que producirían una versión funcionalmente distinta del fármaco.
Al analizar más estos genes, los investigadores pudieron predecir la estructura de esta nueva molécula, a la que llamaron macollaban. Luego sintetizaron químicamente este pariente nunca antes visto de la colistina, produciendo un compuesto novedoso sin necesidad de extraerlo de su fuente natural. Ya en el laboratorio se demostró que la macolacina es potente contra varios tipos de bacterias resistentes a la colistina.
Posteriormente, probaron el nuevo agente en ratones infectados con XDR Acinetobacter baumannii resistente a la colistina , otro patógeno de mayor amenaza. Los ratones que recibieron una inyección de macolacina optimizada eliminaron por completo la infección en 24 horas, mientras que los tratados con colistina o placebo retuvieron al menos la misma cantidad de bacterias presentes durante la infección inicial.
"Nuestros hallazgos sugieren que la macolacina podría potencialmente convertirse en un fármaco para ser utilizado contra algunos de los patógenos resistentes a múltiples fármacos más preocupantes", ha concluido Sean Brady, profesor en la Universidad de Rockefeller.






